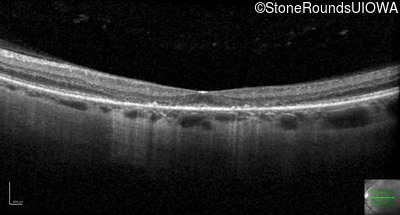
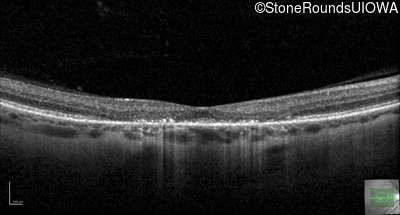
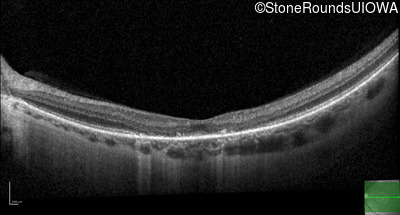

Case
SR7427
Student Mode
AD Stargardt Disease (IIF)
Female
Female
Hidden
SR7427
Student Mode
AD Stargardt Disease (IIF)
Female
Female
History
This 40 year old woman first noticed a reduction of her visual acuity about two years ago. She has been sensitive to light for as long as she can remember.
| Age at visit: 40 years |
Diagnosis & molecular findings
| Disease | Gene | Allele 1 variant(s) | Allele 2 variant(s) | Inheritance mode |
|---|---|---|---|---|
| AD Stargardt Disease | PROM1 | Arg373Cys CGC>TGC | AD |